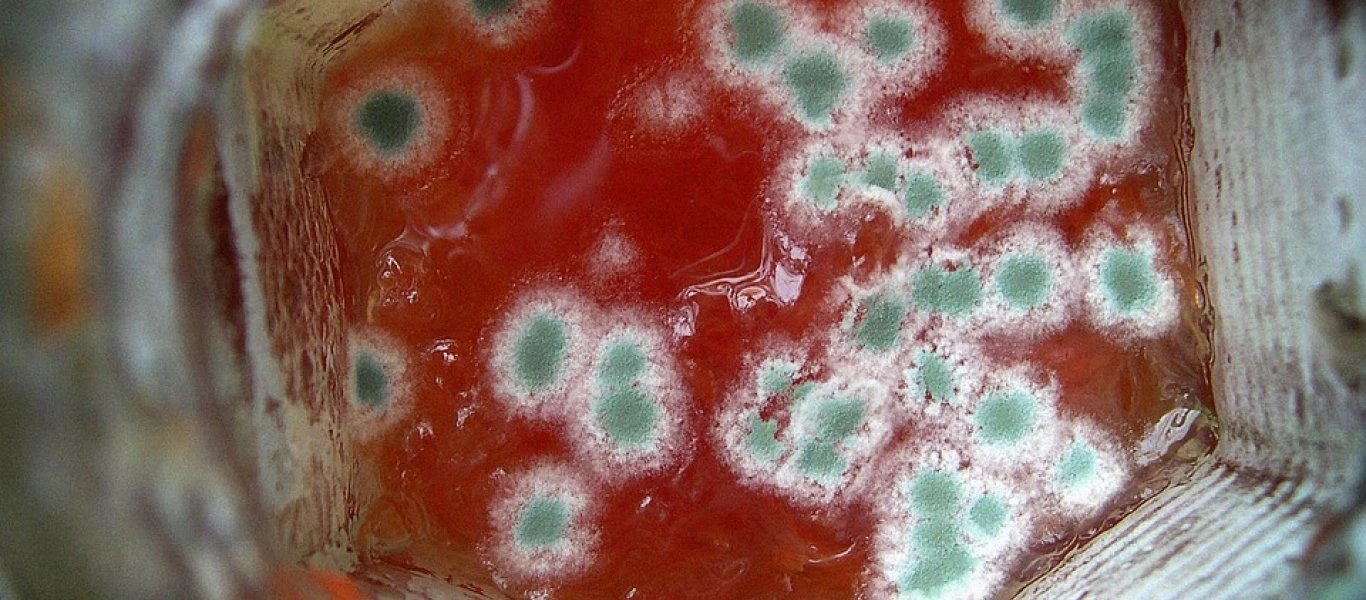
Τι είναι η λιστερίωση και ποια τα συμπτώματα της νόσου;

ΥΓΕΙΑ
-

Αυτά είναι τα βότανα που θα σε βοηθήσουν να αντιμετωπίσεις τις ημικρανίες
Ένα μεγάλο ποσοστό ανθρώπων «βασανίζεται» από συχνές ημικρανίες. Υπάρχουν κάποια βότανα, που μπορούν να ανακουφίσουν από τον πόνο των ημικρανιών και να σας κάνουν να νιώσετε καλύτερα με απόλυτα φυσικό...
Read More » -

Δείτε τι συμβαίνει στον οργανισμό κάθε φορά που πίνετε έστω κι ένα αναψυκτικό
Οι άμεσες επιπτώσεις των αναψυκτικών στον οργανισμό του ανθρώπου είναι καλά τεκμηριωμένες. Περίπου 20 λεπτά αφότου πιείτε ένα κουτάκι αναψυκτικό σας “χτυπά” ένα κύμα ενέργειας: Μόλις έχετε πάρει το 10...
Read More » -

Aυτή η χώρα τρώει περισσότερο κρέας
Οι λόγοι που κάποιος αποφασίζει να μειώσει ή να αφαιρέσει το κρέας από τη διατροφή του ποικίλλουν. Από τη θωράκιση της υγείας, μέχρι την προστασία των ζώων και τις περιβαλλοντικές επιπτώσεις, οι υποστ...
Read More » -

Έτσι θα καθαρίσετε το συκώτι σας - Απαλλαγείτε από τις πέτρες με αυτόν τον τρόπο
Ο καθαρισμός του ήπατος βελτιώνει την πέψη κάτι που αποτελεί τη βάση της καλής υγείας.Λειτουργεί σπουδαία στη θεραπεία των αλλεργιών και επίσης ανακουφίζει τον πόνο στους ώμους, στον άνω βραχίονα, και...
Read More » -

Ο άνθρωπος που έπασχε από σπάνια πάθηση και αφόδευε μια φορά το μήνα - Πέθανε στα 29 του χρόνια (φώτο)
Ένα ιατρικό αξιοπερίεργο που μετατράπηκε σε στολίδι των σόου με φρικιά.Σε μια από τις πλέον περιβόητες και ιστορικές περιπτώσεις χρόνιας δυσκοιλιότητας, έζησε κάποτε ένας άντρας που πέρασε όλη του τη ...
Read More » -
Τι είναι η λιστερίωση και ποια τα συμπτώματα της νόσου;
Η λιστερίωση είναι μια σοβαρή λοίμωξη που συνήθως προκαλείται από την κατανάλωση τροφίμων μολυσμένων με το βακτήριο Listeria monocytogenes (λιστέρια).Η λιστερίωση είναι πιο πιθανό να προσβάλλει έγκυες...
Read More » -

Κριθαράκι στο μάτι: Τι πρέπει να κάνουμε όταν βγαίνει εσωτερικά και τι εξωτερικά
Το κριθαράκι στο μάτι είναι ένα σπυρί ή απόστημα που σχηματίζεται, είτε στο άνω, είτε στο κάτω βλέφαρο. Είναι μια φλεγμονή που προκαλείται από την απόφραξη ενός αγωγού σμήγματος (φυσικό έλαιο της επιδ...
Read More » -

Η «αθώα» ελιά που είχε ήταν μελάνωμα: Του αφαίρεσαν 40 εκατοστά δέρμα (φώτο)
Ένας άντρας διαγνώστηκε με μελάνωμα τον Νοέμβριο του 2018 και μετά από δεκάδες βιοψίες και εγχειρήσεις στο σβέρκο και την πλάτη του, οι γιατροί κατάφεραν να του σώσουν τη ζωή από μια σπάνια μορφή καρκ...
Read More » -

«Έρχεται» το πρώτο φάρμακο που θα καθυστερεί την εξέλιξη του Αλτσχάιμερ
Περισσότερες πιθανότητες να αντιμετωπίσουν το Αλτσχάιμερ έχουν τώρα οι πάσχοντες, καθώς πρόσφατα ερευνητικά δεδομένα φέρνουν στο φως νέα φαρμακοθεραπεία που καθυστερεί την εξέλιξη της νόσου και αναδει...
Read More » -

Δείτε πως φτιάχνονται οι μπάρες πρωτεΐνης (βίντεο)
Έχετε αναρωτηθεί ποτέ πώς φτιάχνονται οι μπάρες πρωτεΐνης που επιλέγετε μετά από τις επισκέψεις στο γυμναστήριο; Βρήκαμε την παραγωγική διαδικασία και μάλιστα σε βίντεο.Για την ακρίβεια, βρήκαμε πώς φ...
Read More »
